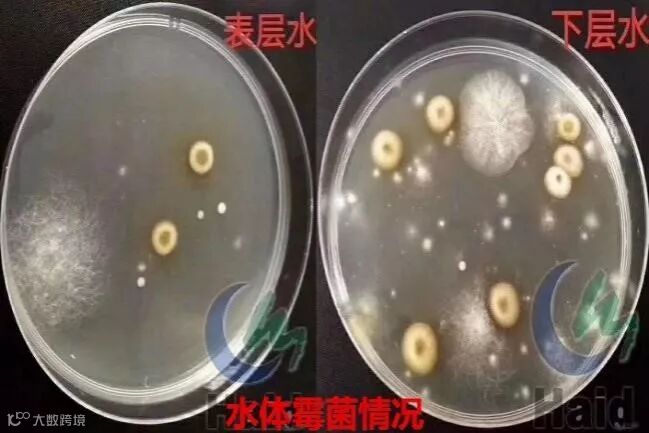

文 | 图 珠海海龙 张志
曾经单斗门白蕉区域,感染水霉的鱼类在高峰期超过30万斤/天!
前 言
随着第一波冷空气杀到,珠海开启入冬模式,不少盲曹苗塘和虾塘悄然盖起冬棚,留下海鲈和黄花等鱼塘在冷风中瑟瑟发抖,随后将面临年度一大考验——水霉!
回顾过去几年,除了暖冬影响较小外,2016年的寒潮影响之大记忆犹新。越冬期水霉不得不防。部分客户朋友一个冬季后,轻则不见几万尾鱼,重则被迫出鱼。据不完全统计,曾经单斗门白蕉区域感染水霉的鱼类在高峰期超过30万斤/天,对养殖业造成了巨大的经济损失!对于水霉病,广大养户越来越重视越冬期的防治工作。这个冬天,拒绝水霉,从现在开始。

一、什么是水霉?
水霉菌广存在于世界各地的淡水或半咸水水域及潮湿土壤中,于死亡的有机物上腐生,为一种常在的霉菌,于10-15℃时最适合生长,25℃以上时繁殖力减弱,不易感染。

水霉早期基本没有症状,当肉眼能发现症状时候,菌丝已经在伤口侵入并向外长出外菌丝,似灰白色的绵毛状,俗称“生毛”或白毛病。霉菌可以分泌大量的蛋白酶,机体受刺激后能分泌大量的粘液。在冬春季节发病率高,一旦发病后治疗困难。

左图:水霉的孢子囊 右图:水霉钩状的菌丝
二、什么样的鱼塘,容易爆发水霉病?
(1) 寄生虫比较多,入冬前杀虫、消毒工作不到位的鱼塘。
通常感染斜管虫和指环虫等寄生虫较多的鱼塘,鱼体被寄生虫咬伤后,出现的伤口极易被水霉寄生和感染。

(2) 平时改底少,水质指标超标的鱼塘。
底质差易引起寄生虫暴发:鱼塘寄生虫主要的传播途径是池塘的底质,且寄生虫的发生也有一定的底质原因。在池塘底质较差时,水体就会出现还原化、酸化、有机化、毒性化。此时底质容易出现发酵产热,为寄生虫卵的孵化提供较好的温度条件,另外池底容易滋生大量的细菌。这些细菌一方面容易导致鱼体发生疾病;另一方面也能够被寄生虫所摄食,有利于寄生虫的大量快速繁殖,导致寄生虫病的暴发和传染。
底质差会导致水质和鱼体质变差:因为改底少,池塘底部氧债过高,养殖中后期往往容易出现氨氮高、亚盐高。鱼体在水质差的环境中,长期处于应激透支状态,体质和抵抗力持续减弱。一旦寒潮来临时,鱼群在水体中上层容易被冻伤,当体表出现寄生虫虫口和机械损伤时,水霉感染几率会大大增加。

(3) 存塘密度比较大,池塘溶氧偏低。
尾批鱼由于平时控制投喂,鱼体长期处于营养不足的亚健康状态。再加上高密度的养殖环境和平时保健内服工作的缺失,在寒潮这些环境波动比较大的天气下,容易感染水霉。
三、水霉防治建议
(1) 具有优越条件的鱼塘,可搭棚、抽地下咸水、加深水位等方式给水体保温防寒,或者及时开塘降低存塘密度。(抽地下水的养户朋友,注意谨防水质指标超标,和进行重金属解毒,解毒可用海联科3201)

(2) 入冬前后做好杀虫消毒以及增强体质的工作,促进鱼体抵抗力增强及损伤愈合,定期检查寄生虫是否再次感染。杀虫可配合使用内服驱虫的和生堂阿苯达唑,强体可使用海联科肝肠利健。
和生堂阿苯达唑
(3) 降低氨氮亚盐,保障池塘溶氧,定期使用海联科3202。
海鲈塘每天一包3202效果
盲曹和立鱼塘每天一包3202效果
(4) 越冬早改底,定期改底或者肥水等方式改良水体环境。
建议冬季要保持每10天改底一次,并且在寒潮来临之际,提前2天进行改底处理。建议使用海联科3202/底倍健/菌速清/粒粒氧改底组合。
寒潮改底组合

底倍健+改底

秋冬肥水

总结语
对于海水鱼养殖来说,冬季的最大风险就是水霉发病,水霉病的发生与否只是表观的现象,但深入分析就是看广大养户的养殖意识是否到位,有没有主动进行改底、消毒杀虫、内服等一系列预防工作,预防工作到位了,才能够真正安全越冬,实现轻松养殖!
注:想了解更多海联科产品,请在海大农牧公众号上输入“海联科”,即可查询。
海大农牧
接地气的水产一线技术
长摁二维码,即刻关注

